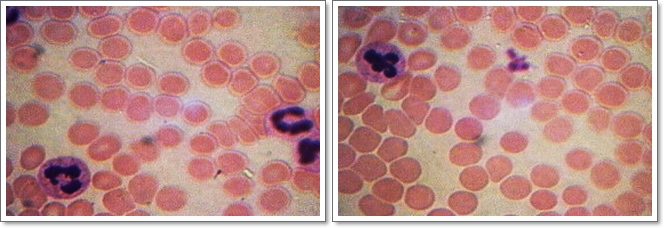

|
|
En els animals:
En els éssers vius hi ha importants processos de diferenciació celúlular. Les cčlúlules tenen morfologies i funcions molt diferenciades i específiques.

Els teixits:
Igual que en les societats humanes, en tots els organismes multicelúlulars es manifesta una divisió del treball i una diferenciació fisiolňgica que origina els teixits, que es poden definir com el conjunt de cčlúlules idčntiques que realitzen una determinada activitat de forma coordinada. Moltes vegades, les membranes es fusionen per formar un embolcall que les manté juntes, mentre que d'altres estan colúlocades de forma a‹llada.

Organs, aparells i sistemes:
Un ňrgan és una estructura funcional constitu‹da per diversos teixits, que estŕ encarregat de dur a terme un acte (funció unitŕria) determinat: per exemple, el cor és un ňrgan que distribueix la sang per tot l'organisme, i estŕ constitu‹t per teixit muscular, epitelial, conjuntiu i nerviós.
El conjunt d'ňrgans que, malgrat que siguin molt diferents en l'estructura i el funcionament, realitzen junts i coordinats un determinat procés (funció complexa) rep el nom d'aparell; seguint amb l'exemple del concepte anterior, l'aparell circulatori inclou ňrgans molt diferents, com el cor, els vasos sanguinis, els conductes limfŕtics i els nňduls nerviosos reguladors. Cada un realitza una funció unitŕria prňpia, perň tots plegats duen a terme el procés de circulació dels líquids corporals i d'interconnexió química dels diferents órgans. Més endavant, en el nivell creixent de complexitat dels éssers vius, arriba el concepte de sistema. Un sistema és un conjunt d'ňrgans constitu‹ts bŕsicament pels mateixos teixits, i de naturalesa similar, perň de complexitat molt diferent, que realitzen la seva funció prňpia en tot l'organisme, de forma jerarquitzada i coordinada amb la resta: podríem citar com a exemples característics l'encčfal, la medulúla espinal, els nervis i els detectors sensorials, que en conjunt formen el sistema nerviós.

Hi ha una altra definició de sistema: conjunt d'ňrgans semblants que realitzen funcions independents. Així, podríem parlar del sistema muscular, on cada múscul té una funció determinada, a vegades completament independent. Un exemple d'aixň podrien ser els músculs del braç i els de la cama que, essent de la mateixa naturalesa, realitzen accions independents.
Aparell circulatori:
L'aparell circulatori és el conjunt format pel cor i els vasos que permeten la circulació dels fluids corporals, i pot esser: - Obert, quan els vasos no constitueixen un circuit complet, i es comuniquen per unes cavitats que són omplertes per la sang, quan en surt. - Tancat, si la sang circula sempre per l'interior dels vasos i només en surt quan arriba als capilúlars. Per altra part, segons la complexitat dels circuits es poden distingir dos tipus de circulació: senzilla o doble. Si la sang passa tan sols una vegada pel cor en cada volta al cos, es diu senzilla, perň si hi passa dues vegades, es diu doble NOTA: la circulació doble pot esser també de dues classes:Ş2Incompleta: Quan la sang oxigenada -que ve dels pulmons- i la que ve dels teixits es mesclen en passar pel cor.Ş2Completa: Quan no ho fan, perquč hi ha dos ventricles separats.
Tall transversal d'artčria:

L'estructura de la paret de les artčries ha de permetre suportar les ones de pressió produ‹des per la sang bombejada pel cor. Per tant, una artčria típica té tres capes ben diferenciades: La túnica interior de les artčries estŕ formada per teixit conjuntiu llis, que permet el pas fluid de la sang. La túnica mitjana és gruixuda i conté membranes elŕstiques separades per fibres musculars llises. Dóna fortalesa i capacitat de variació del diŕmetre. La túnica externa és una beina conjuntiva, que reforça el conjunt.
Tall transversal de vena:

Per raó que la pressió sanguínia és molt menor que a les artčries, la paret de la vena és mes prima que la de les artčries, i no és elŕstica, manté sempre el mateix diŕmetre. La capa intermčdia té molt de teixit conjuntiu, menys elŕstic que en les artčries. En algunes venes es poden trobar vŕlvules que impedeixen retrocedir a la sang, encara que són molt més abundants als vasos del sistema limfŕtic.
Sang humana:
L'observació microscňpica de la sang sol tenir dos objectius; bé comptar els elements que la constitueixen o bé constatar la presčncia de microorganismes. Farem un frotis sobre un portaobjectes estenent bé amb el cobreobjectes o amb una barreta de vidre i procurant que quedi al més fi possible. Ho deixarem assecar a l'aire i ho fixarem amb alcohol. Després de tenyir-ho amb el mčtode Giemsa, observarem els elements següents: - Els glňbuls vermells o eritrňcits amb hemoglobina
- Els leucňcits
- Leucňcits poc colorejats (neutrňfils).
- Tenyits uniformement de morat
- Tenyits de vermell (eosionňfils) Per cada leucňcit, hi ha a la sang entre 600-800 glňbuls vermells i hem de pensar que en una persona adulta en trobam 5 milions per milúlímetre cúbic.
Per conservar la sang podem utilitzar el líquid de Hayem
L'aparell digestiu:
L'aparell digestiu transforma els aliments, extraient les molčcules que els constitueixen per tal que puguin incorporar-se al metabolisme celúlular. Aquest procés, prou complicat, rep el nom de digestió. En la digestió dels metazous podem diferenciar les etapes següents:
- Trituració de l'aliment, feta per estructures complementŕries, molt variables segons les diverses espčcies.
- Preparació de l'aliment, que estŕ a cŕrrec dels enzims produ‹ts per les glŕndules digestives.
- Absorció dels nutrients (constituents bŕsics dels aliments). Els nutrients creuen les parets de l'intestí i s'incorporen al torrent circulatori, que els durŕ a les cčlúlules.
- Separació i expulsió dels constituents dels aliments que no són aprofitables com a nutrients.
L'esňfag:

L'esňfag es un tub de parets fortes i flexibles, que comunica la faringe amb l'entrada de l'estómac. L'estructura de la paret és molt semblant a la de la resta de l'aparell digestiu: Una túnica mucosa, que permet que els aliments passin fŕcilment, sense rosegament. Túnica submucosa (recorreguda pels vasos sanguinis). Túnica muscular, encarregada de produir les contraccions peristŕltiques característiques del tub digestiu. Túnica externa de teixit conjuntiu, que dóna consistčncia al conjunt.
L'estómac:

En l'ésser humŕ és una única cavitat i té una capacitat d'1,5 litres. A l'interior es troben nombroses glŕndules, que són les encarregades de segregar els sucs gŕstrics. Per tal d'esmicolar i mesclar els aliments, la paret de l'estómac es mou contínuament amb moviments peristŕltics, i arrossega la mescla d'aliments i sucs digestius que conté cap a la sortida, tancada per un esfínter anomenat pílor que s'obre de forma intermitentper tal de deixar sortir petites quantitats cap a l'intestí prim.
L'intestí prim:

L'intestí prim és un tub que en l'ésser humŕ té una llargŕria aproximada d'1,5 metres. Es troba arreplegat dins l'abdomen i es fixa a la paret posterior mitjançant una membrana conjuntiva molt resistent, anomenada mesenteri La mucosa forma uns plegaments en forma d'anell i estŕ recoberta per petites vellositats molt juntes. Aixň augmenta la superfície útil de l'intestí, cosa que afavoreix l'absorció de les substŕncies nutritives. La superfície interna estŕ recoberta de glŕndules productores de suc digestiu intestinal
L'intestí gruixut:

L'intestí gruixut té 3 segments: cňlon ascendent, cňlon transvers i cňlon descendent. La mucosa, doblegada, té nombroses vellositats. En aquesta zona es troben poques glŕndules. No té funció digestiva coneguda, i bŕsicament es dedica a l'absorció d'aigua i algunes vitamines produ‹des per bacteris simbiňtics que hi viuen. La funció principal és l'emmagatzemament delsexcrements fins al moment de l'expulsió, regulada per l'acció d'un esfínter de contracció voluntŕria, anomenat anus. En l'home és capaç d'absorbir uns 6 litres d'aigua diaris.
Fetge d'ovella:

Es troba sota el diafragma i a prop de l'estómac. El fetge humŕ pesa 1,5 kg. Funcionalment té dues parts diferents: 1. Produeix la bilis per emulsionar els greixos, i altres substŕncies adients per a la neutralització del quim 2. Regula la concentració sanguínia dels nutrients, elimina de la sang, per transformació química, moltes substŕncies perjudicials, sintetitza prote‹nes de la sang, etc. És la glŕndula més gran i la que té més funcions de tot l'organisme.
L'aparell respiratori:

És complementari de l'aparell digestiu, i la seva funció consisteix a fer arribar l'oxigen a les cčlúlules de l'organisme. L'oxigen és transportat de dues formes: dissolt en els fluids del medi intern, o combinat amb unes substŕncies anomenades pigments respiratoris, que són unes prote‹nes complexes, variables segons el tipus d'animal. En els vertebrats realitza aquesta funció l'hemoglobina, situada als glňbuls vermells, i que és la responsable del color vermell de la sang.
Els pulmons:

Els pulmons són uns ňrgans constitu‹ts per nombroses cavitats molt petites, amb les parets extremadament primes, fetes d'epiteli monoestratificat anomenades alvčols. D'aquesta manera augmenta la superfície i es pot realitzar amb eficŕcia l'intercanvi de gasos amb la sang, que circula per capilúlars molt prims entorn dels alvčols; per donar una certa consistčncia, la resta dels espais estŕ emplenada amb teixit conjuntiu.
L'aparell reproductor:

La reproducció és la formació de nous individus.
La reproducció sexual és el sistema emprat per la quasi totalitat dels éssers, perquč presenta molts avantatges. En els metazous es realitza a partir de gŕmetes, que són cčlúlules originades a les gňnades (ovaris i testicles) per meiosi i per tant amb la meitat dels cromosomes que la resta de les cčlúlules, anomenades cčlúlules somŕtiques
Trompa uterina
És un conducte d'una llargŕria de diversos centímetres, que té la missió de transportar els ňvuls madurs fins a l' úter grŕcies a nombrosos cilis mňbils que entapissen la paret interna. És interessant fer constar que la fecundació es produeix sempre dins les trompes, i no dins l'úter; l'ňvul fecundat segueix el camí vers l'úter, i es fixa a l' endometri (la paret interna), originant l'ňrgan de connexió amb la mare, que és la placenta. (abaix esquerra)

Testicle de porc
Exemple representatiu de gňnada masculina, perquč l'estructura dels testicles de tots els mamífers és similar i dissenyada a base de tres parts diferenciades: una coberta fibrosa i resistent, centenars o milers de conductes seminífers encarregats de la producció dels espermatozoides, que es troben en gran quantitat i envoltats, i l'estroma, que és un teixitconjuntiu lax molt vascularitzat. Les cčlúlules intersticials tenen funció endocrina i produeixen l'hormona masculina anomenada testosterona
(Dalt dreta)
Epidídim de porc
És el conducte encarregat de completar la maduració dels espermatozoides, que avancen lentament a mida que experimenten el procés. Té, igual que el testicle -al qual estŕ aferrat-, una coberta fibrosa, i acaba al principi del conducte deferent, que duu els espermatozoides fins a les vesícules seminals, per constituir la base de l' ejaculació Com a dada curiosa podem dir que el volum del líquid de l'ejaculació de l'home i del toro és normalment de 3-3,5 cc, mentre que en el porc és de 250 cc (Baix esquerra)

Ovari d'ovella
És el lloc de formació dels ňvuls, és a dir, la gňnada femenina, i estŕ constitu‹t per dues zones diferenciades: la zona medulúlar, molt rica en vasos sanguinis, i la zona cortical, on es poden apreciar gran quantitat de folúlicles de Graaf, que són els llocs on es desenvolupen els ňvuls. (Dalt dreta).
L'aparell excretor:

Estŕ encarregat de l'expulsió dels productes residuals del metabolisme celúlular, com el diňxid de carboni, l'amoníac, l'ŕcid úric i la urea. És important no confondre el concepte d'excreció, que és el que comentam, amb la defecació, que és l'expulsió de les restes d'aliments no aprofitats en el procés de digestió intestinal. En els mamífers estŕ format per un parell de ronyons, que són les estructures filtrants, dos určters que condueixen l'orina i una bufeta; en alguns animals inferiors, i segons la seva complexitat, pot ser suficient amb unes estructures més senzilles anomenades protonefridis En tot cas, el procés bŕsic és sempre una filtració selectiva.
Els ronyons:
Són dos ňrgans de color vermellós localitzats a la regió lumbar. La sang entra als ronyons per les artčries renals. Els ronyons separen l'excés d'aigua, diverses sals minerals, substŕncies diverses com els medicaments i els metabolits que resulten com a subproducte de la digestió celúlular delsaliments, i que si quedassin a la sang tendrien efectes tňxics. L'observació del tall ens permet diferenciar: - Zona cortical - Zona medulúlar - Pelvis renal La zona cortical i la zona medulúlar contenen els tubs urinífers, que recullen l'orina produ‹da per les unitats filtrants, anomenades nefrones i que s'agrupen en unes estructures anomenades pirŕmides de Malpighi. Els tubs urinífers aboquen, a través de les papilúles renals que hi ha als včrtexs de les pirŕmides, en la cavitat central del ronyó, anomenada pelvis renal, que té forma d'embut i recull l'orina formada; dels ronyons surten uns tubs anomenats určters que condueixen l'orina a la bufeta, d'on anirŕ a l'exterior. (Baix esquerra).

Les glŕndules sudorípares:
Són un petits tubs que produeixen la suor, que és un líquid de composició semblant a la de l'orina perň menys concentrat, i que aboquen a l'exterior de la pell per uns petits forats anomenats porus. La suor intervé en la regulació de la temperatura, ja que quan s'evapora pren calor de la superfície de la pell, que per tant baixa la temperatura. Serveix també de petit complement a l'acció de l'aparell excretor. (Dalt dreta).
El fetge:
En el fetge s'eliminen productes que formen la bilis, quetambé s'utilitza per a la digestió intestinal.
El sistema nerviós:
La seva funció consisteix a regular i dirigir el funcionament de tots els ňrgans del cos, captant amb receptors específics totes les variacions, tant interiors com exteriors a l'organisme que es puguin produir, elaborant una resposta adequada i fent que aquesta resposta sigui duita a terme mitjançant els ňrgans efectors. Moltes vegades, el procés de comunicació i de transmissió de les respostes es fa en colúlaboració amb el sistema_endocrí En l'ésser humŕ, el sistema nerviós és molt complex, i tédues parts diferenciades:
- Sistema nerviós cerebroespinal, que regula les funcions de relació i els moviments voluntaris. - Sistema nerviós autňnom, que regula de forma involuntŕria i sense coneixement conscient el funcionament general de l'organisme.
Cerebel:

Estŕ situat a la part darrera del cervell, i és l'ňrgan encarregat del control precís dels moviments voluntaris, és a dir, si el cervell decideix fer qualque moviment, dóna l'ordre i es desenté; el cŕlcul de la quantitat precisa de tensió en cada múscul i l'elecció dels músculs que han d'intervenir són responsabilitat del cerebel.
Cervell:

És el centre més important del sistema nerviós. Controla el funcioname de la resta de centres nerviosos i de vísceres del cos, i és el centre de la sensibilitat general i de les facultats intelúlectuals.
De forma directa o indirecta controla i regula les anomenades "constants vitals", és a dir, manté constants els nivells de gran quantitat de parŕmetres, com la pressió sanguínia, la temperatura del cos, la composició de la sang, etc. A l'igual que la resta del sistema nerviós, estŕ constitu‹t per neurones, agrupades de forma que els cossos celúlulars queden vers la part exterior (substŕncia grisa), i les connexions a la part interior (substŕncia blanca).
Per donar una idea de la seva complexitat, basta dir que el cervell humŕ conté 10 000 milions de neurones interconnectades i coordinades.
| |